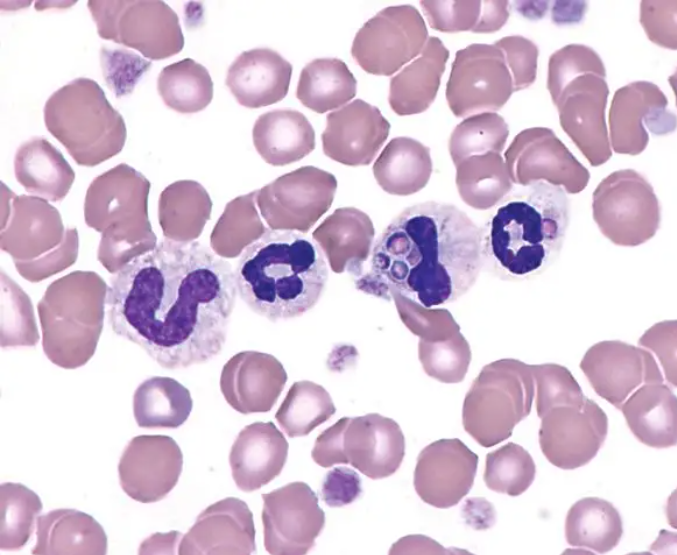
骨髓涂片.png

天津有濟醫(yī)藥科技發(fā)展有限公司臨床檢驗實驗室擁有BECKMAN COULTER全自動生化分析儀、SIEMENS血液分析儀、STAGO凝血分析儀等國際頂尖儀器設(shè)備,可以開展生化檢驗、凝血功能檢驗、血液學檢驗、尿生化檢驗、血涂片檢查、骨髓涂片檢查等多學科領(lǐng)域檢驗項目,能夠嚴格按照GLP規(guī)范和ISO15189質(zhì)量體系要求建立了完善、科學、嚴謹?shù)馁|(zhì)量管理制度。

【圖】生化分析儀

【圖】凝血分析儀

【圖】血液分析儀
【圖】骨髓涂片
在有濟醫(yī)藥卓越的技術(shù)團隊的努力下,首次提交的“血清生化檢驗”、“血液學檢驗”、“凝血功能檢驗”、“尿生化檢驗”等項目,即全部獲得中檢院“結(jié)果滿意”認定,標志著公司出具的每一份檢測數(shù)據(jù)均具有可信度和質(zhì)量保證,預示著有能力為藥物毒理學、藥效學研究提供可靠、規(guī)范的數(shù)據(jù)支持。
此次能力驗證順利通過是有濟醫(yī)藥技術(shù)平臺建設(shè)的階段性成果,也是未來GLP體系建設(shè)和臨床中心實驗室建設(shè)的重要標志。未來,有濟醫(yī)藥將繼續(xù)秉持精益求精,新益求新的精神,不斷加強各個平臺的技術(shù)建設(shè),不斷優(yōu)化質(zhì)量管理,還會獲得更多國際、國內(nèi)行業(yè)權(quán)威、標準認證,更好服務(wù)新藥研發(fā)事業(yè)。
—關(guān)于有濟醫(yī)藥— 業(yè)務(wù)聯(lián)系:13636617420 招聘聯(lián)系:18920495817 網(wǎng)址:http://yugenmed.com
天津有濟醫(yī)藥科技發(fā)展有限公司(簡稱有濟醫(yī)藥)是凱萊英醫(yī)藥集團(股票代碼:002821.SZ / 06821.HK)旗下聚焦于新藥的藥理、毒理、藥代評價領(lǐng)域,為創(chuàng)新藥物研發(fā)提供早期成藥性篩選、臨床前藥理毒理整包評價、臨床階段臨床藥理學研究與生物樣品檢測服務(wù)的CRO公司。總部位于天津經(jīng)濟技術(shù)開發(fā)區(qū),在上海浦東新區(qū)自貿(mào)壹號生命科學園設(shè)有實驗室,總設(shè)施面積超過13000㎡。
有濟醫(yī)藥憑借對國內(nèi)外法規(guī)的深層理解、對藥物開發(fā)與評價策略的精準分析、豐富的新藥評價實戰(zhàn)經(jīng)驗、完善的質(zhì)量管理體系,為國內(nèi)外新藥研發(fā)機構(gòu)和制藥企業(yè)提供覆蓋藥理、毒理、藥代評價的全流程、一站式臨床前及臨床研究技術(shù)服務(wù)。




